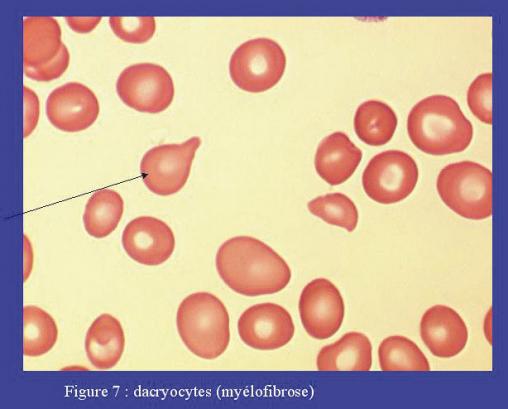

Les dacryocytes sont des globules rouges en forme de larme. Leur présence doit évoquer en premier lieu une myélofibrose. Ils peuvent être retrouvés, au sein d’une poïkilocytose non sytématisée, dans différentes pathologies: les cancers métastatiques de la moelle osseuse, les thalassémies, les anémies hémolytiques toxiques, les carences en vitamines B12 ou en folates